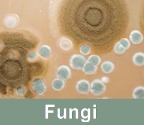

Call for Carpet Cleaning Appt.

24 HOUR EMERGENCY
SERVICE AVAILABLE
- Carpet Cleaning
- Carpet Repair
- Stain Removal
- Area Rug Cleaning
- Oriental Rug Cleaning
- Fast-Dry Cleaning
- Pet Odor Neutralization
- Pet Damage Cleaning
- Mildew Extraction
- Mold Remediation
- Disinfect / Sanitize
- Air Duct Cleaning
- Chimney Cleaning
- Water Removal
- Water Damage Restoration
- Tile & Grout Cleaning
Call for Carpet Cleaning Appointment


Servicing the Following Areas:
Auburndale, FL., Avon Park, FL., Bartow, FL., Belleair, FL., Belleair Beach, FL., Belleair Bluffs, FL., Bradenton, FL., Bradenton Beach, FL., Brooksville, FL., Bushnell, FL., Clearwater, FL., Clearwater Beach, FL., Dade City, FL., Dunedin, FL., Dunnellon, FL., Hudson, FL., Gulfport, FL., Kenneth City, FL., Kissimmee, FL., Lake Alfred, FL., Lakeland, FL., Lake Mary, FL., Lake Wales, FL., Largo, FL., Longboat Key, FL., Madeira Beach, FL., New Port Richey, FL., North Port, FL., North Redington Beach, FL., Ocala, FL., Oldsmar, FL., Orlando, FL., Palmetto, FL., Pinellas Park, FL., Plant City, FL., Polk City, FL., Port Richey, FL., Redington Beach, FL., Safety Harbor, FL., St. Pete Beach, FL., St. Petersburg, FL., Sanford, FL., Sarasota, FL., Seminole, FL., Sunrise, FL., Tampa, FL., Tarpon Springs, FL., Temple Terrace, FL., Treasure Island, FL., Weeki Wachee, FL., Winter Garden, FL., Winter Springs, FL., Zephyrhills, FL., and Other Surrounding Cities.
Air Duct Cleaning
As a family owned business we understand the importance of healthy family living. That's why we provide professional air duct cleaning services in Tampa, FL. We offer a wide range of residential and commercial cleaning services including air duct cleaning, dryer vent cleaning, chimney sweeps, power wash and mold remediation.
We want to make sure the quality of the air you and your family breath in is clean. Often the most overlooked household and commercial services are the cleaning of your air ducts, performing a regular chimney sweep and cleaning your dryer vents. When air vents are not maintained and kept clean build up of dust particles, pollen, mold and other debris contaminate your vents and are released through the air you breathe. When dryer vents and chimneys are not cleaned and maintained, lint and Creosote buildup and pose a fire hazard. That's why having our professionals come to service your air ducts, dryer vents, and performing chimney sweeps and mold remediation on a consistent basis is so important.


Get Cleaner Air

Cleaning the Dryer Vent, improves the safety and efficiency of your dryer. As the dryer vent fills with lint and other debris drying time increases, and can cause the dryer itself to overheat.
Preventing accumulation of lint throughout the dryer exhaust system will make your dryer work at its best. When lint builds up in the dryer vent it prevents air and moisture* from escaping the dryer and clothes remain damp.
Running the dryer more than a 40 minute cycle results in a waste of time, energy, and causes unnecessarily high energy bills.
*One load of wet clothes placed in a dryer contains about 1/3 gallon of water. Clothes dryers are one of the most expensive appliances in your home to operate. The longer they run, the more money they cost you.
The U.S. Consumer Product Safety Commission estimates that 15,500 fires associated with clothes dryers occur annually causing 10 deaths, 310 injuries, and more than $84.4 million in property damage annually. Lack of maintenance is the leading cause of dryer fires, with lint cited as the leading material to ignite.

CALL US NOW
1-800-520-6040
Late Night
Weekends
Holidays

Keeping your home or office safe from harmful air pollutants and vent fires is our job and we do it well!
Call our office for a free quote today and breathe a little easier.
727-723-2432





Tampa, Florida
Call Us Now @
727-723-2432
1-800-520-6040



Copyright © Checkpoint Cleaning Service - P.O. Box 5801, Clearwater, FL, 33758 - 727-723-2432 - All Rights Reserved.

**Avoid Breathing Potentially Harmful Pollutants'**
Don't Breath Dirty Air...
Call Us to Clean Your Air Vents!



Following Information found on the EPA (Environmental Protection Agency) website.
We're Fast to Get the Job Done Right!

Allergies Lower Immune Systems!

*** WARNING - Potential Fire Hazard ***
Don't Forget Your Dryer Vents and Exhausts!
Benefits of Regular Cleaning Your Air Ducts:
- Allergies - Improves the quality of the air coming through your Air Vents.
- Saves $$$ - Keeping your Heating and Cooling Systems clean helps it run more efficiently and reduces the amount of energy to run.
- Peace of Mind - Knowing that your Air Ducts are clean brings you peace of mind about the quality of the air that flows through your Air Ducts.
- Reduce Odors - Keeping your Air Ducts and Heating and Cooling System clean helps remove musky and moldy odors.
- Efficiency - Heating and Cooling Systems have longer life of their parts and equipment when kept cleaning and maintained.
The Best Carpet Steam Cleaning Service in the Tampa, Florida Area!